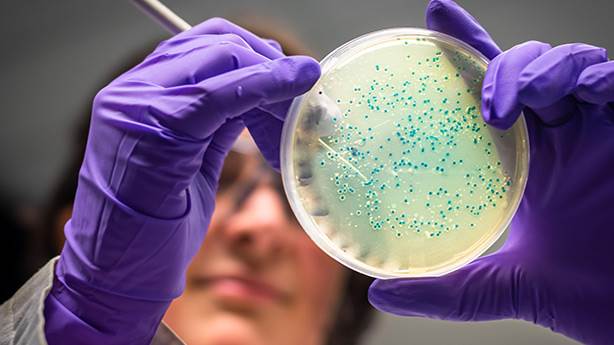

ABD'de soğan alarmı! Hemen çöpe atın
ABD'de 3 yüzlerce kişiyi hasta eden 'salmonella' salgınının arkasında Meksika'dan ithal edilen soğanlar çıktı. Yetkililer "Aldığınız soğanların nereden geldiklerini bilmiyorsanız hemen çöpe atın uyarısında bulundu.
ABD genelinde 650'den fazla kişiyi hasta eden'Salmonella' salgınının sebebinin Meksika'nın Chihuahua kentinden ithal edilen soğanlar olduğu ortaya çıktı. Hastalık Kontrol ve Önleme Merkezi (CDC) insanlardan evlerindeki ve iş yerlerindeki soğanlarını kontrol etmelerini istedi.
HEMEN ÇÖPE ATIN, TEMAS ETMİŞ YÜZEYLERİ STERİLİZE EDİN
Yapılan uyarıda "Aldığınız soğanların nereden geldiklerini bilmiyorsanız hemen çöpe atın.Bu soğanlarla temas etmiş olabilecek tüm yüzeyleri yıkayın ve sterilize edin" ifadesi yer aldı.
KIRMIZI, BEYAZ, SARI HEPSİ RİSKLİ
CDC, Meksika'nın Chihuahua kentinden ithal edilen kırmızı, beyaz ve sarı soğanların hepsinin uyarıya tabi olduğunu söyledi.

ProSource isimli bir şirketin hastalığa neden olan soğanları ABD genelindeki market ve restoranlara dağıttığı bildirildi. Yapılan açıklamada "Soğanlar 27 Ağustos'ta Meksika'dan ithal edildi ancak depoda üç aya kadar bekleme süresi olduğu düşünüldüğünde ürünler hala evlerde ve işyerlerinde olabilir." denildi.
37 EYALETTE, 652 KİŞİ HASTA
CDC'ye göre, soğanlara bağlı 'salmonella vakası' ilk olarak 1 Eylül'de ortaya çıktı. Hastalık 37 eyalette 652 kişide görüldü. Salgında şu ana kadar can kaybı yaşanmadı ancak 129 kişi hastaneye kaldırıldı.
Teksas, Oklahoma, Virginia, Maryland ve Illinois, bildirilen en yüksek vaka sayısına sahipti. Vaka bildiren diğer eyaletler ise şöyle; California, Oregon, Güney ve Kuzey Dakota, Utah, Colorado, New Mexico, Nebraska, Kansas, Missouri, Arkansas, Minnesota, Iowa, Wisconsin, Louisiana, Mississippi, Alabama, Tennessee, Georgia, Kuzey ve Güney Carolina, Florida, Kentucky, Indiana, Michigan, Ohio, Batı Virjinya, Pensilvanya, New Jersey, Connecticut, Massachusetts ve New York.
KAYNAK: HÜRRİYET
|
Yorumcuların dikkatine… • İmlası çok bozuk, • Büyük harfle yazılan, • Habere değil yorumculara yönelik, • Diğer kişilere hakaret niteliği taşıyan, • Argo, küfür ve ırkçı ifadeler içeren, • Bir iki kelimelik, konuyu zenginleştirmeyen, yorumlar KESİNLİKLE YAYIMLANMAYACAKTIR. |
Bu haber henüz yorumlanmamış...
Bunlar da ilginizi çekebilir...


































































































